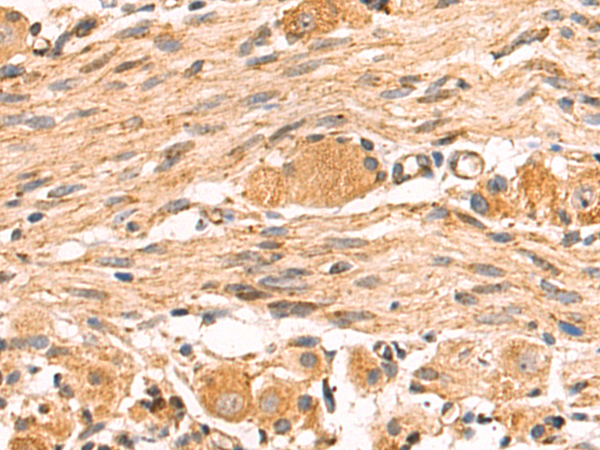

Background:
This is a component of the ubiquinol-cytochrome c reductase complex (complex III or cytochrome b-c1 complex), which is part of the mitochondrial respiratory chain. This protein may mediate formation of the complex between cytochromes c and c1.
Applications:
ELISA, WB, IHC
Name of antibody:
UQCRH
Immunogen:
Fusion protein of human UQCRH
Full name:
ubiquinol-cytochrome c reductase hinge protein
Synonyms:
QCR6; UQCR8
SwissProt:
P07919
ELISA Recommended dilution:
5000-10000
IHC positive control:
Human colorectal cancer and Human prostate cancer
IHC Recommend dilution:
50-200
WB Predicted band size:
11 kDa
WB Positive control:
Rat heart tissue and Mouse heart tissue lysates
WB Recommended dilution:
200-1000

購物車
購物車 幫助
幫助
 021-54845833/15800441009
021-54845833/15800441009
